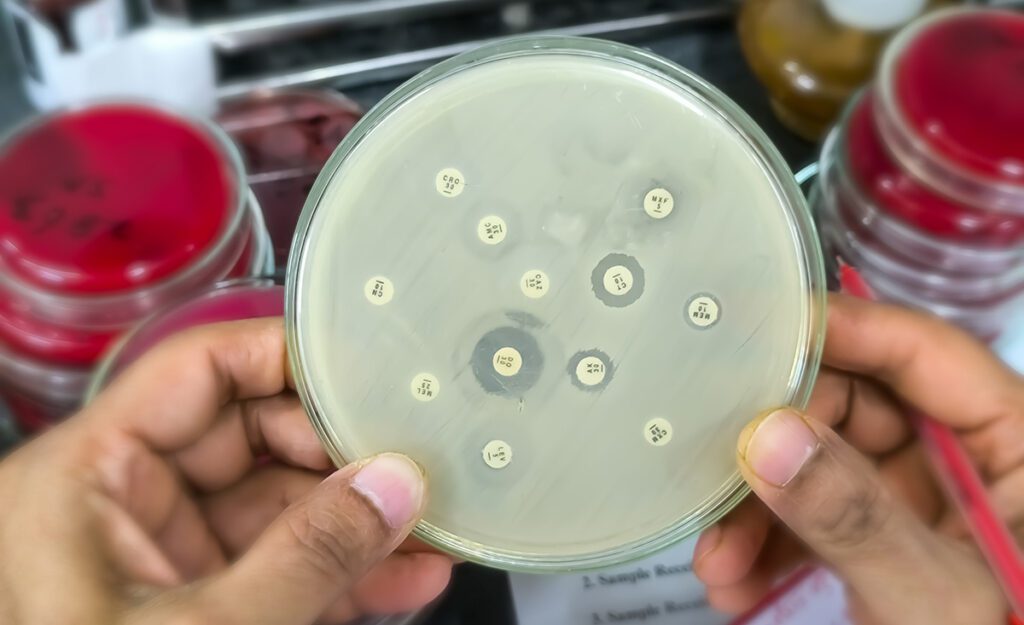

Antimicrobiële gevoeligheidstest in een petrischaal | Foto: Adobe Stock
Naast de ontwikkeling van nieuwe generaties antibiotica en vaccins, bekijken onderzoekers ook het effect van antimicrobiële peptiden, bacteriofagen of combinaties van antibacteriële middelen.
De verminderde werking van antibiotica noopt tot een zoektocht naar alternatieven om bacteriën effectief te bestrijden. In de strijd tegen resistentie leiden er meerdere wegen naar Rome, waaronder vaccinatie, antimicrobiële peptiden, bacteriofagen, koud plasma en zelfs het oernatuurmiddel ‘honing’.
Nieuwe generatie antibiotica en vaccins
De strijd tegen bacteriële infecties werd eerder gewonnen door de continue ontwikkeling van nieuwe antibiotica. Nu stokt deze ontwikkeling door de snelle toename van resistentie, hoge ontwikkelkosten en gebrek aan tijd. Het kan wel tien jaar duren voordat een nieuw middel beschikbaar is door de strenge testen voor effectiviteit en veiligheid.
Daarom zijn alternatieve behandelingen van cruciaal belang. Ook is het een feit dat farma meer interesse heeft in de ontwikkeling van nieuwe therapieën voor welvaartsziekten, omdat hier nu eenmaal meer geld mee te verdienen valt.

tk1 Optie 1: vaccins voor pathogene bacteriën
Een van de alternatieven voor antibiotica zijn vaccins voor pathogene bacteriën. Op dit vlak is er het nodige onderzoek gaande. Met een vaccinatie wordt het immuunsysteem getraind om een ziekteverwekker te herkennen en snel op te ruimen. De preventieve werking van vaccins vermindert de afhankelijkheid van antibiotica en vertraagt de ontwikkeling van resistentie.
“Een veelbelovend alternatief zijn antimicrobiële peptiden: deze eiwitstructuren kunnen bacteriën effectief doden door hun celwand te beschadigen”
tk2 Optie 2: antimicrobiële peptiden
Omdat de ontwikkeling van vaccins tijdrovend en duur is, wijken onderzoekers ook uit naar andere alternatieven. Een veelbelovend alternatief zijn antimicrobiële peptiden. Deze eiwitstructuren, vaak van natuurlijke oorsprong of afgeleid daarvan, kunnen bacteriën effectief doden door hun celwand te beschadigen.
Denk bijvoorbeeld aan de ontstekingscellen in ons bloed. Deze ontstekingscellen produceren verschillende antimicrobiële peptiden, bijvoorbeeld defensinen, waaronder alfa-defensine, en cathelicidinen, zoals LL-37.
Deze antimicrobiële peptiden pakken meestal een evolutionair geconserveerd deel van de bacterie aan of grijpen zelfs op meerdere targets tegelijk aan. Dat verlaagt de kans op het ontwikkelen van resistentie tegen deze peptiden aanzienlijk.
“Een groot voordeel van bacteriofagen is ook dat deze virussen geen schade toebrengen aan het lichaam en de gezonde bacteriën in ons microbioom”
tk3 Optie 3: bacteriofagen
Vijand van de vijand gebruiken, dat doen bacteriofagen. Bacteriofagen zijn virussen die specifiek bacteriën infecteren en doden. Er bestaan er verschillende voor diverse bacteriesoorten. Het gebruik van bacteriofagen om bacteriën te bestrijden biedt daarom een gerichte aanpak. Een groot voordeel van bacteriofagen is ook dat deze virussen geen schade toebrengen aan het lichaam en de gezonde bacteriën in ons microbioom. Deze aanpak is compleet anders dan antibiotica, die meestal ook het microbioom beschadigd.
Bacteriofagen zijn daarom een interessante optie voor patiënten met hardnekkige, resistente infecties. Het UMC Utrecht onderzoekt zelfs genetisch aangepaste bacteriofagen die nog beter werken, wat een veelbelovende stap is in de strijd tegen antibioticaresistentie. Voordat dokters bacteriofagen voor zullen schrijven, moet er eerst nog meer onderzoek gedaan worden naar de effectiviteit van deze virussen.
tk4 Optie 4: honing en koud plasma
Naast antimicrobiële peptiden en bacteriofagen onderzoeken wetenschappers ook het gebruik van alternatieve middelen, zoals honing en koud plasma, om pathogene bacteriën te bestrijden.
Honing remt bacteriële groei dankzij zijn lage pH, hoge osmotische druk en de productie van waterstofperoxide. Specifieke soorten, zoals Manuka-honing, bevatten methylglyoxal, een krachtig antibacterieel middel dat in sommige gevallen zelfs effectief is tegen resistente bacteriën.

Rauwe Manuka honing
Koud plasma is een geïoniseerd gas dat bestaat uit elektronen, ionen en reactieve moleculen. Het werkt door reactieve zuurstof- en stikstofsoorten te genereren, die bacteriën en biofilms vernietigen. Daarnaast blijkt het in bepaalde situaties ook de wondgenezing te kunnen bevorderen.
tk5 Optie 5: antibioticum en peptide, een krachtige combi
Het combineren van antibiotica met antimicrobiële peptiden kan een synergetisch effect opleveren. Dit biedt nieuwe invalshoeken in de bestrijding van resistente bacteriën. Een voorbeeld hiervan is de combinatie antibioticum colistine met bepaalde cationische peptiden, die samen de bacteriële celmembraanstructuur verder destabiliseren, waardoor de werking van het antibioticum wordt versterkt.
Ook is aangetoond dat beta-lactam-antibiotica effectiever kunnen zijn in combinatie met peptiden die de celwand verzwakken. Dergelijke combinaties kunnen niet alleen de effectiviteit verhogen, maar ook de benodigde dosering van antibiotica verlagen, wat bijdraagt aan een verminderd risico op resistentieontwikkeling.